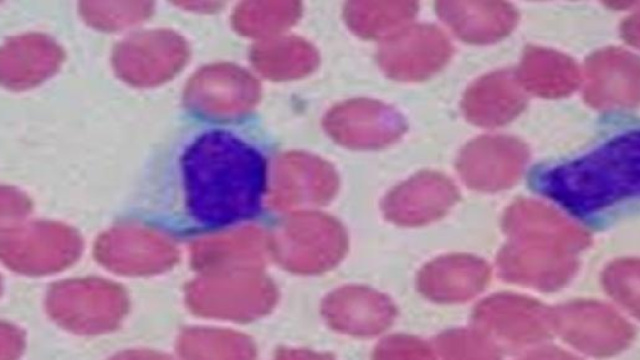
Test sangue e saliva per diagnosticare cancro

Un'indagine scientifica ha consentito di individuare, in pazienti affetti da tumori della testa e del collo, l'esistenza di queste patologie attraverso l'analisi del Dna presente nella saliva e nel sangue. La ricerca, condotta da un gruppo di ricercatori della Johns Hopkins University School of Medicine a Baltimora insieme ad altri Istituti e pubblicata su Science Translational Medicine, potrebbe consentire l'elaborazione di test diagnostici non invasivi capaci di svelare precocemente questi tumori. Secondo gli studiosi, infatti, un banale test di questi fluidi potrebbe in futuro permettere una diagnosi precoce e un miglior controllo del cancro alla testa e al collo.
Questi tumori colpiscono diversi organi (cavo orale, laringe, faringe, bocca, lingua, naso e altre regioni all'interno della testa e del collo) e possono anche essere innescati dal Papilloma Virus umano (HPV).
In linea generale, i tumori rilasciano particelle di Dna all'interno di saliva, sangue e urina. Questi frammenti si rivelano come distintive alterazioni genetiche del Dna originario e sono presenti in detti fluidi in concentrazioni molto ridotte, rendendo particolarmente difficile la loro individuazione.
Ricerca scientifica
Nello studio citato, i ricercatori hanno prelevato campioni di saliva e/o di sangue a 93 pazienti colpiti da carcinoma a cellule squamose della testa e del collo. Tutti i pazienti hanno fornito campioni di saliva e 47 tra loro anche campioni di sangue. Mediante le analisi effettuate, il Dna tumorale è stato individuato nella saliva di 71 dei 93 pazienti (76%) e nel sangue di 41 dei 47 pazienti (87%). Inoltre, un test che ha analizzato sia il sangue sia la saliva, ha individuato il DNA del tumore nel 96% dei pazienti.I test sulla saliva si sono dimostrati maggiormente efficaci nel trovare i tumori della cavità orale, anche in fase iniziale, mentre i test sul plasma sono risultati particolarmente adatti per individuare i tumori del collo e della gola in stadio avanzato.
Prospettive future
Partendo da questo studio, si pensa che in un prossimo futuro un semplice test della saliva potrebbe essere eseguito dal dentista o anche a casa su pazienti ritenuti ad alto rischio, facilitando così l'individuazione della patologia ancora prima che compaiano i sintomi. Sia in caso di cancro in fase iniziale sia in caso di recidiva, la diagnosi precoce può infatti rendere migliore la qualità della vita e può alzare la percentuale di sopravvivenza.
Dobbiamo però sottolineare che nessuna persona completamente sana è stata sottoposta, nel corso di questa indagine scientifica, all'analisi dei fluidi. Dovrà essere proprio questa la prossima mossa della ricerca, indirizzata a stabilire se il DNA del tumore che si rinviene nella saliva e nel sangue sia realmente in grado di anticipare convenientemente la comparsa del cancro.